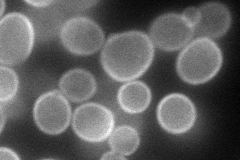
YLR004C

View description
Putative plasma membrane permease proposed to be involved in carboxylic acid uptake and repressed by thiamine; substrate of Dbf2p/Mob1p kinase; transcription is altered if mitochondrial dysfunction occurs
Localization:
Intensity:
Fold change:
Significance:
-
C’ GFP library in SD

below threshold16.01 -
N' NOP1pr-GFP in SD
cell periphery108.822 -
N' TEF2pr-mCherry in SD

cell periphery,vacuole216.498 -
N' NATIVEpr-GFP in SD

below threshold16.3841 -
N' TEF2pr-VC and Cyto-VN in SD

cell periphery48.0235 -
C’ GFP library in SD+DTT

cytosol15.540.97No -
C’ GFP library in SD+H2O2

cytosol14.990.93No -
C’ GFP library in Starvation Media

cytosol18.441.15No -
C’ GFP library on the background of Pup2-DaMP

below threshold -
C’ GFP library on the background of CCT mutant

below threshold14.84780.927181No
